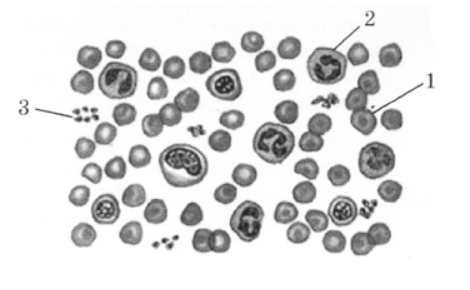
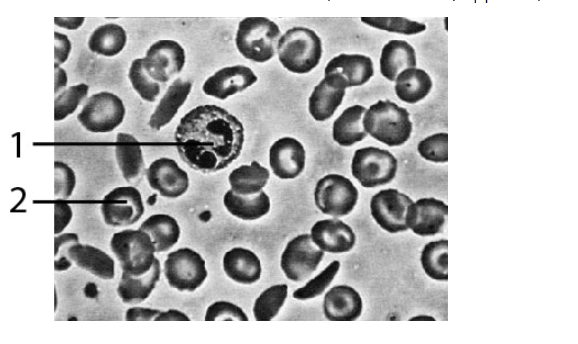

Внутрішнє середовище організму людини.
Укажіть місце формування (1) і руйнування (2) еритроцитів крові людини.
Визначте складники крові людини за їхньою характеристикою: без’ядерні клітини, мають форму двоввігнутого посередині диска, утворюються в червоному кістковому мозку, руйнуються в селезінці й печінці.
Проаналізуйте твердження щодо значення йонів Феруму для організму людини.
І. Йони Феруму є складниками молекул гемоглобіну.
ІІ. Нестача в організмі людини йонів Феруму може спричинювати анемію.
Чи є поміж них правильні?
Визначте складники крові за їхньою характеристикою: безбарвні, мають ядро, утворюються в червоному кістковому мозку, руйнуються в селезінці та місцях запалення.
Які особливості будови еритроцитів крові людини забезпечують ефективність дихальної функції?
Укажіть функцію, яку виконує гемоглобін.

Перетворення гемоглобіну А на аномальну форму S може призводити до
Фізіологічний розчин, яким розбавляють лікарські препарати для введення в кров
На рисунку зображено формені елементи крові людини. Укажіть правильний варіант підписів до рисунку.
Лейкоцити крові здійснюють
Прочитайте речення, де пропущено окремі слова та словосполучення, позначені цифрами. Укажіть правильний варіант відповіді.
Гемоглобін - це (1) білок, що міститься в (2).
На рисунку зображено сполучну тканину. Проаналізуйте рисунок і вкажіть правильні твердження.
І. Істотне збільшення кількості клітин, позначених цифрою 1, викликає лейкопенію.
ІІ. Істотне зменшення кількості клітин, позначених цифрою 2, викликає анемію

Створюйте онлайн-тести
для контролю знань і залучення учнів
до активної роботи у класі та вдома


















